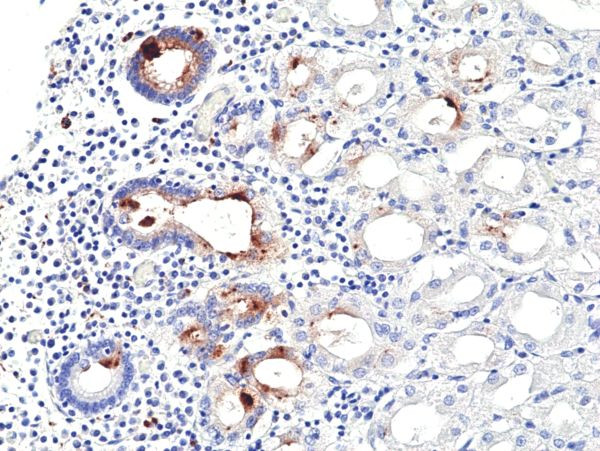
Helicobacter pylori Antibody in Immunohistochemistry (Paraffin) (IHC (P))

Search
Invitrogen
Helicobacter pylori Recombinant Rabbit Monoclonal Antibody (RM429)
{{$productOrderCtrl.translations['antibody.pdp.commerceCard.promotion.promotions']}}
{{$productOrderCtrl.translations['antibody.pdp.commerceCard.promotion.viewpromo']}}
{{$productOrderCtrl.translations['antibody.pdp.commerceCard.promotion.promocode']}}: {{promo.promoCode}} {{promo.promoTitle}} {{promo.promoDescription}}. {{$productOrderCtrl.translations['antibody.pdp.commerceCard.promotion.learnmore']}}
产品信息
MA5-44564
种属反应
宿主/亚型
Expression System
分类
类型
克隆号
抗原
偶联物
形式
浓度
规格
纯化类型
保存液
内含物
保存条件
运输条件
RRID
靶标信息
Helicobacter Pylori (H. Pylori) is known to cause peptic ulcers and chronic gastritis in human. It is associated with duodenal ulcers and may be involved in development of adenocarcimona and low grade lymphoma of mucosa associated lymphoid tissue in the stomach. It is a microaerophilic gram-Negative bacterium, helix-shaped, and with many diverse strains.
仅用于科研。不用于诊断过程。未经明确授权不得转售。
篇参考文献 (0)
生物信息学
蛋白别名: H. pylori